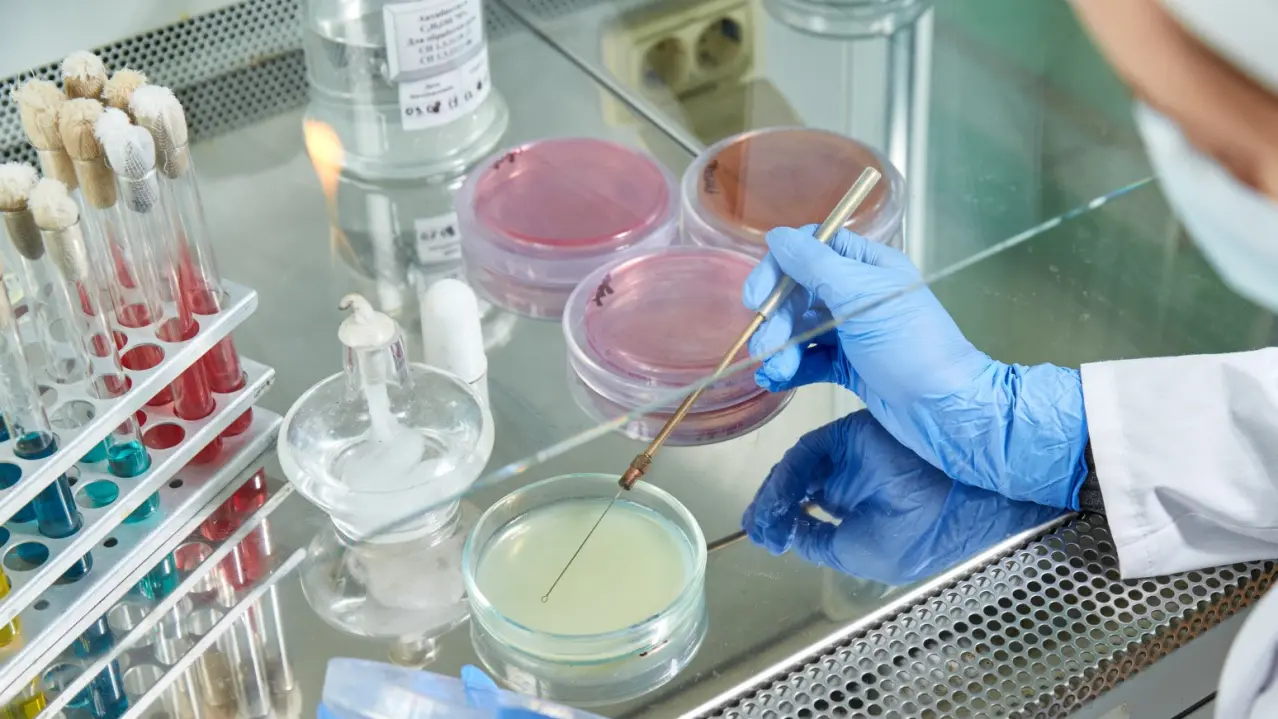

درباره برنامه آموزشی
تضمین ایمنی بیولوژیکی مواد غذایی وظیفه اصلی پزشک دامپزشکی است. این برنامه با هدف آموزش متخصصان بسیار ماهر در زمینه تشخیص عفونت های بسیار خطرناک و کنترل کیفیت محصولات گیاهی و دامی است. متخصصان این حوزه در موسسات دولتی و خصوصی که به تشخیص آزمایشگاهی و کنترل کیفیت محصولات غذایی می پردازند، مورد تقاضا هستند. علاوه بر دانش نظری، دانشجویان روش های اصلی انجام باکتریولوژی، شیمی و سم شناسی را فرا می گیرند.